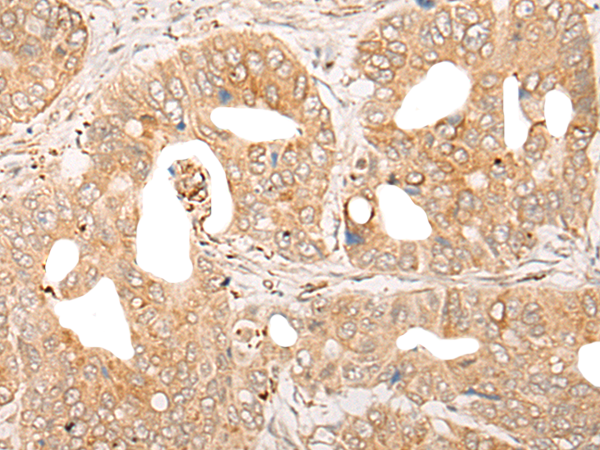

中文名稱:兔抗CPNE6多克隆抗體
|
Background: |
This gene encodes a member of the copine family. Members of this family are calcium-dependent, phospholipid-binding proteins with C2 domains, two calcium- and phospholipid-binding domains. Through their domain structure and lipid binding capabilities, these proteins may play a role in membrane trafficking. This protein is thought to be brain-specific and has a domain structure of two N-terminal C2 domains and one von Willebrand factor A domain. It may have a role in synaptic plasticity. |
|
Applications: |
ELISA, IHC |
|
Name of antibody: |
CPNE6 |
|
Immunogen: |
Fusion protein of human CPNE6 |
|
Full name: |
copine 6 |
|
SwissProt: |
O95741 |
|
ELISA Recommended dilution: |
5000-10000 |
|
IHC positive control: |
Human gastric cancer |
|
IHC Recommend dilution: |
25-100 |
購(gòu)物車
購(gòu)物車 幫助
幫助
 021-54845833/15800441009
021-54845833/15800441009
